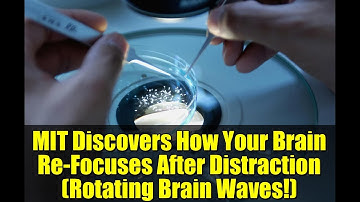
MIT Discovers How Your Brain Re-Focuses After Distraction (Rotating Brain Waves!)

⬇ DOWNLOAD NOW
Kalau muncul iklan pop-up, tutup lalu klik tombol kembali
Download lagu A world first trial using brainwave simulation to slow cognitive decline | Sunrise secara gratis hanya untuk keperluan promosi. Dukung artis favorit kamu dengan membeli musik original di iTunes atau platform resmi lainnya.
 The First Clinical Trial to Reverse Cognitive Decline
The First Clinical Trial to Reverse Cognitive Decline
 🧠 Microdosing Simulation | Gentle Transformation Path + Sustained Neuroplasticity
🧠 Microdosing Simulation | Gentle Transformation Path + Sustained Neuroplasticity
 40Hz Stimulation Slows Cognitive Decline in Late-Onset Alzheimer's - New Study
40Hz Stimulation Slows Cognitive Decline in Late-Onset Alzheimer's - New Study
 Dementia Simulation Experience Features
Dementia Simulation Experience Features
 HEALS a DAMAGED Brain at the Neurological Level (EMDR Binaural & Bilateral Gamma Wave QT4 Frequency)
HEALS a DAMAGED Brain at the Neurological Level (EMDR Binaural & Bilateral Gamma Wave QT4 Frequency)
MIT Discovers How Your Brain Re-Focuses After Distraction (Rotating Brain Waves!)
MIT Discovers How Your Brain Re-Focuses After Distraction (Rotating Brain Waves!)
 40Hz Sensory Stimulation: A Breakthrough in Alzheimer's Treatment? | MIT Research Explained
40Hz Sensory Stimulation: A Breakthrough in Alzheimer's Treatment? | MIT Research Explained
 IT'S HERE ❯❯❯ The Dementia "MIRACLE" Gamma Repair Frequency (40Hz)
IT'S HERE ❯❯❯ The Dementia "MIRACLE" Gamma Repair Frequency (40Hz)